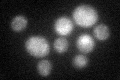
YAL039C

View description
Cytochrome c heme lyase (holocytochrome c synthase), attaches heme to apo-cytochrome c (Cyc1p or Cyc7p) in the mitochondrial intermembrane space; human ortholog may have a role in microphthalmia with linear skin defects (MLS)
Localization:
Intensity:
Fold change:
Significance:
-
C’ GFP library in SD

mitochondria18.8 -
N' NOP1pr-GFP in SD

mitochondria83.2317 -
N' TEF2pr-mCherry in SD

missing0 -
N' NATIVEpr-GFP in SD

below threshold16.1497 -
N' TEF2pr-VC and Cyto-VN in SD

#N/A0 -
C’ GFP library in SD+DTT
mitochondria20.781.1No -
C’ GFP library in SD+H2O2

mitochondria14.440.76No -
C’ GFP library in Starvation Media

mitochondria26.111.38No -
C’ GFP library on the background of Pup2-DaMP

mitochondria -
C’ GFP library on the background of CCT mutant

mitochondria15.10970.803552No
